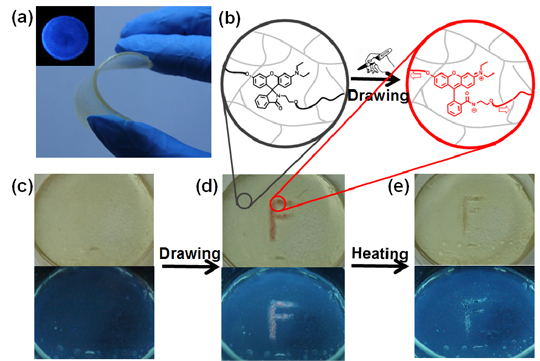

2020年春节突如其来的疫情牵动着亿万人民的心,也几乎打乱了大部分公司的工作计划和部署。尤其是客服中心人力密集,全国疫情防控严峻,权威媒体《客户世界》呼吁客服行业企业联合起来提供疫情期间客户服务中心(呼叫中心)应急方案指导,环信第一时间响应,提出了应对本次疫情应急方案的思考和实践。同时,环信视频客服从1月28日(大年初四)对全国所有参与疫情防治的政府机关、医院、企业、公益组织等提供的免费服务,目前已经有数十家医疗机构和企业申请开通正常运行中。
客户服务中心疫情应急方案思考和实践指导思想:
一,技术类措施:通过技术手段,将座席分散、业务分散;
二,运营类措施:管理分散的座席,保障服务品质;
三,人员替代措施:引导使用自主渠道,智能化AI工具,进一步机器替代人工;

大部分企业的客户服务中心(职场)都是人员特别密集的格子间布局。抗疫隔离,说起来难,做起来更难。以下是客户服务中心切换到远程工作模式的详细行动计划,供参考。
01STEP自查当前系统,能不能远程工作?
自查当前使用的呼叫中心和在线客服系统,是云的还是私有部署。如果是云的,那么你可以松一口气。至少从技术上来说,客服远程工作没什么的大的阻碍。
如果是私有部署,赶紧联系你的软件供应商。少部分系统通过小幅度的改造,可以支持远程公网访问。但大部分的系统改造起来比较难,不是二三天能搞定的。
这种情况下,请跳转Step 02.
02STEP切换到云的方案
如果你的系统是私有部署,而且不支持远程公网访问,赶紧联系云呼叫中心和云在线客服的供应商吧。
你需要搞清楚以下几个问题:
问题1:切换到云的呼叫中心和在线客服,要花多少钱?
你可能只是想临时过渡一下,以前自己那套私有部署的呼叫中心还没折旧完呢。临时切换到云的呼叫中心和在线客服,要花多少钱?好在云服务形式的供应商,基本上都是按需付费,可以按年按月按席位数来动态付费。所以价格应该不是问题。
问题2:怎么切换?
1.在线客服系统切换到云:在线客服系统很容易切换。只要请IT部门改一下自己官网或微信公共账号的客服系统咨询链接就可以了,几行代码,几分钟搞定。
2.呼叫中心切换到云:呼叫中心的切换会费劲些。主要的工作是把提供服务的400/95/固话号码迁移到云呼叫中心厂商那里去。如果迁移服务号码实在有困难,最差的情况是企业公布一个临时的新的客服电话。特殊时期,客户也都可以理解的。至少可以在过渡时期为原来的客服电话入口做一些分流。这个新的客服电话入口背后对应的客服都在家办公,都使用新的云呼叫中心系统。
PS:在选型供应商时,建议选能同时提供呼叫中心+在线客服一体化的全媒体客服的厂家。不然给2家公司付费、培训使用2套系统、2套系统数据还不打通,很麻烦的。
03STEP调整电话和在线的入口比例
在家办公,呼叫中心对环境和设备的要求比在线客服高多了。比如网络环境不能太差,否则通话音质无法保障。需要公司给配置电脑笔记本,配置耳麦话机等。此外,在家办公的环境还需要安静不打扰。有点难。
相比之下,在线客服要求就低多了。网络环境只要能聊微信,基本就够用。生产设备只需要一个电脑,别的都不用。所以在特殊时期,如果要真的把在家办公落地,一定要做的事情就是尽量收窄电话客服入口,尽量放大在线客服入口。
具体的操作包括:1.发布公告,请用户尽量使用在线服务;在各个用户可能看到的地方,都放上尽可能显眼的在线客服的入口。2.电话入口在IVR在排队时不断提醒用户电话客服少,请用户尽量使用在线;
04STEPAI是第一生产力,尽量多用一些AI
在线客服上AI,“在线客服+客服机器人”的黄金组合已经逐渐成为了行业标配,落地效果明显。所以建议在线客服尽量把文字客服机器人用起来。用的好的企业的文字机器人,大多能实现30%以下的转人工率。也就是说,100个对话,现在有70个被机器人解决了,不用转人工了,相当于节约了70%的人力。
如若转载,请注明e科网。
如果你有好文章想发表or科研成果想展示推广,可以联系我们或免费注册拥有自己的主页
- 环信
- 智能客服


 我要投稿
我要投稿